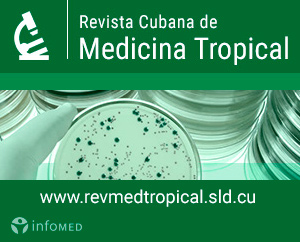

La Biblioteca Virtual en Salud de Cuba (BVS) y la Editorial Ciencias Médicas (ECIMED) anuncian la publicación del número más reciente de la Revista Cubana de Medicina Tropical, que se corresponde con el Vol. 72, No. 2 (2020).
Usted puede consultar la tabla de contenidos donde encontrará los artículos que sean de su interés. Le recomendamos especialmente los siguientes trabajos:
Artículos especiales
- The chronic kidney disease epidemic in El Salvador: the influence of agrochemicals
- Apuntes sobre la experiencia cubana en el enfrentamiento a la COVID-19
Artículos originales
- Caracterización clínica del paludismo importado
- Evaluación de una reacción en cadena de la polimerasa en tiempo real simple y rápida para la cuantificación del ADN del virus de la hepatitis B
La Revista Cubana de Medicina Tropical integra la colección de Revistas Médicas Cubanas, disponible a través de la Biblioteca Virtual en Salud de Cuba. Publica artículos científicos especializados en medicina tropical, microbiología, parasitología, epidemiología y otras especialidades afines. Fue fundada en 1945 y es continuadora de la Revista "Kuba". Los artículos enviados son sometidos a un proceso de evaluación por pares (peer review).
Enviar un comentario nuevo